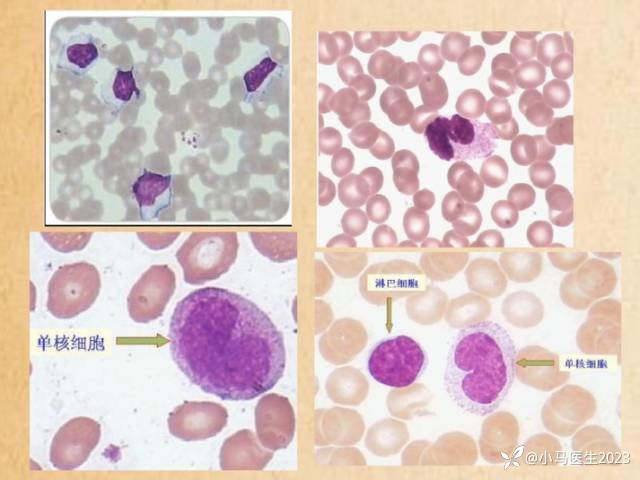
img

【详解】传染性单核细胞增多症
芒果三岁 推荐传染性单核细胞增多症(IM),简称传单,又叫接吻病或者亲吻病。多见于学龄前及学龄儿童,主要由飞沫与唾液经呼吸道传播,其次经密切接触传播。

6岁以下患儿常为轻症或隐性感染,病后可获得持久性免疫。病程2-3周,具有自限性,预后良好。
本病多由EB病毒感染所致,少数可由巨细胞病毒、弓形虫、腺病毒、肝炎病毒、HIV等引起。血白细胞总数正常、升高或减少,可先正常或减少,1周末升高,淋巴细胞增多,血涂片中异型淋巴细胞比例≥10%。
血清EB病毒抗体测定,早期抗原(EA)-IgG效价≥1:20,病毒衣壳抗原(VCA)-IgM阳性或效价≥1:10,VCA-IgG效价≥1:160,或VCA-IgG在恢复期比急性期升高4倍以上,EB核抗原在病程3-4周阳性。分子生物学方法检测血液、唾液、口腔上皮细胞、尿液中的EB病毒DNA阳性,骨髓检查基本正常。
临床诊断
1.症状
以下症状至少3项以上阳性:①发热;②咽炎、扁桃体炎;③颈部淋巴结肿大(大于1cm);④肝大;⑤脾大。
2.血象检查
(1) 白细胞分类淋巴细胞>50%或淋巴细胞总数≥5.0×10⁹/L;
(2)异型淋巴细胞≥10%或总数≥1.0×10⁹/L。
3.EB病毒抗体检查
急性期EB核抗原阴性,并有以下之一项:
(1) 抗VCA-IgM抗体初期阳性,以后转阴;
(2) 双份血清抗VCA-IgG抗体滴度4倍以上升高;
(3) EA抗体一过性升高;
(4) VCA-IgG抗体初期阳性;EB病毒核抗原抗体后期阳转。
4.EB病毒DNA检查
血液、唾液、口咽上皮细胞、尿液或组织中的EB病毒DNA阳性。
5.EB病毒抗原检查
鼻咽拭子直接测定抗原阳性。
符合上述临床症状和血象检查,同时具备第3-5项之一,可确诊。
异型淋巴细胞俗称“异淋”,是抗原刺激后的一类转化型细胞,其细胞核和细胞质都有形态学改变,特征为细胞体积增大,细胞质嗜碱性增强,出现空泡,细胞核变大,染色质疏松、甚至出现核仁,是一种形态异常的淋巴细胞。
异型淋巴细胞也有资料称为:变异淋巴细胞、不典型淋巴细胞和反应性淋巴细胞,主要容易与单核细胞混淆。所以,我们的一些前辈们把传染性单核细胞增多症中的异型淋巴细胞增生误认为是单核细胞,因而就产生了传单这个病名!
异形淋巴细胞分三型:

Ⅰ型(空泡型),此型最为常见
淋巴细胞胞体大小正常或稍大,多呈圆形。胞核圆形、椭圆形、肾形或不规则形。核染色质致密、粗糙,呈不规则聚集。胞质量中等,深蓝色,常有空泡,一般无颗粒。

Ⅱ型(不规则型)
胞体较淋巴细胞明显增大,外形不规则。胞核圆形、椭圆形,可见不规则形。核染色质致密、浓染,可见不规则聚集。胞质量丰富,淡蓝色,边缘较深染,可见少量嗜苯胺蓝颗粒。

Ⅲ型(幼稚型)
胞体较大,多呈圆形。胞核大,呈圆形或椭圆形,核染色质较细致,可见1-2个核仁。胞质量较少,呈深蓝色,多不见颗粒,可见少数空泡。
异型淋巴细胞指Downey氏三型淋巴细胞,除三型特指异型淋巴细胞外,所有的被抗原或生物活性激活剂激活导致染色质和细胞形状改变的均为激活淋巴细胞,即活化淋巴细胞,活化淋巴细胞均归属异型淋巴细胞之列。
异型淋巴细胞生长发育也是动态的,胞体必须大于5个红细胞,胞浆质感厚重、呈裙边形状(即靠近核处色浅,细胞边缘处色深),小于4个红细胞体积大小的归属过渡型。
异型淋巴细胞与单核细胞主要区别:异型淋巴细胞的胞浆像春天肥沃土地树上生长的绿叶,而单核细胞的胞浆则像秋天贫瘠土地树上被虫子啃过的残叶。
是粒是单,先看衣衫,先易到难,先浆到核。
I型异淋与中幼红、浆细胞的鉴别

II型异淋与单核细胞的鉴别

III型异淋与原淋、原单的鉴别

鉴别诊断
1.急性淋巴细胞白血病
传染性单核细胞增多症和急淋白血病某些临床特征有较为相似之处。如二者均好发于青少年;均可出现发热、咽痛、淋巴结肿大、肝、脾肿大、WBC增高等。
传染性单核细胞增多症患者淋巴细胞增高,白细胞分类时淋巴细胞常>40%,中性粒细胞相对减低,但常可见核左移。异型淋巴细胞>10%,若异型淋巴细胞以Ⅰ型 或Ⅱ型者为主,由于其形态特征明显而易于诊断。但若以幼稚型居多时,则需根据其他检验方可确诊。
如血清EB病毒抗体(IgM)阳性,对传染性单核细胞增多 症急性期的诊断具有重要意义。
急淋白血病患者除WBC增高外,多伴有贫血和PLT减低,血片中可见数量不等原淋巴细胞及幼淋巴细胞。骨髓检验二者截然不 同。急淋白血病时骨髓中有核细胞极度增生,以原淋巴细胞为主,>30%,PAS反应(糖原染色)呈强阳性。80%左右急淋白血病为B淋巴细胞型,白血病细 胞主要表达CD10、CD19、CD22、 CD20、cyCD79a等B淋巴细胞免疫标志。
白血病时还可有遗传学变异。传染性单核细胞增多症患者骨髓中淋巴细胞百分比正常或仅轻度增高,可见少量异 型淋巴细胞且异型淋巴细胞多属T淋巴细胞。
2.淋巴细胞慢性增殖性疾病
淋巴细胞慢性增殖性疾患如慢性淋巴细胞白血病、毛细胞白血病、幼淋巴细胞白血病及巨球蛋白血症等其临床特征与传染性单核细胞增多症有所不同,多好发于老年 人,起病隐匿,进展较慢,可表现肝、脾、淋巴结肿大。
异常细胞多分化较好,形态特点较为明确。但某些形态变异或不典型病例,仅凭细胞形态学不足以作出诊断 时,尚需加以鉴别。此时根据骨髓检验、细胞化学染色、细胞免疫表型、某些血清学检验如血清蛋白测定、免疫球蛋白测定、免疫电泳、透射电镜及扫描电镜等进一 步明确诊断。
3.传染性淋巴细胞增多症
传染性淋巴细胞增多症也好发于儿童,但患儿可无任何症状及异常体征,部分患儿表现低热或轻微上呼吸道感染症状,无肝、脾肿大,无全身淋巴结肿大。
患者WBC增高,可达(20-30)×10⁹/L,甚至更高,白细胞分类可见淋巴细胞明显增高,可>60%,重者可>90% 。但增生的淋巴细胞多为成熟的小淋巴细胞,偶见异型淋巴细胞。嗜异凝集试验阴性,EB病毒抗体阴性。传染性淋巴细胞增多症与柯萨奇病毒、12型腺病毒等感染有关。
治疗
以对症支持治疗为主,多数患者可以自愈。该病的并发症种类较多,应提高警惕,必要时针对性治疗。
一般治疗
1.发热高于38.5℃可对症退热,可使用布洛芬、对乙酰氨基酚等退热药,退热出汗后注意多饮水。
2.加强营养支持,多进食高蛋白的食物。
3.充分休息,过度劳累可导致本病加重或反复。
药物治疗
1.常用药物有阿昔洛韦、更昔洛韦等,这些药物通过抑制EB病毒DNA聚合酶而抑制EB病毒裂解感染,但对潜伏性感染无效。
2.抗生素对该病治疗无效,仅在继发细菌感染时使用。忌用氨苄西林和阿莫西林,以免引起超敏反应,加重病情。
3. 重症患者发生咽扁桃体严重病变或水肿、神经系统病变、心肌炎、溶血性贫血、血小板减少性紫癜等并发症时,可应用短疗程糖皮质激素,使用时必须慎重。
手术治疗
若患者出现脾破裂的并发症时,需要接受外科手术进行治疗。
















































